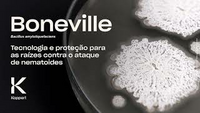

Utilizar para
Deve ser aplicado, de forma preventiva, em áreas com histórico de nematoides fitopatogênicos presentes no solo.
Pragas
Boneville protege a planta contra os nematoides fitopatogênicos:
- Nematoide-das-galhas (Meloidogyne incognita);
- Nematoide-das-galhas (Meloidogyne javanica);
Aplicam-se as condições gerais da Koppert (Koppert B.V. e/ou de suas empresas afiliadas).
Utilize apenas produtos permitidos no seu país/estado e para a sua cultura. Cumpra sempre os
registos locais. A Koppert não se responsabiliza pelo uso não autorizado. A Koppert não se
responsabiliza pela perda de qualidade se o produto for armazenado por mais tempo que o recomendado
e/ou sob condições incorretas.
Proteção à saúde humana, animal e ao meio ambiente. Atenção: uso exclusivamente agrícola. Venda sob receituário agronômico quando exigido por legislação. Consulte sempre um engenheiro agrônomo. Siga rigorosamente as instruções contidas no rótulo, na bula e na receita. Utilize sempre os equipamentos de proteção individual. Nunca permita a utilização do produto por menores de idade. Faça o manejo integrado de pragas. Periculosidade ambiental e demais informações, vide rótulo, bula e receita. Evite contaminação ambiental, preserve a natureza. Descarte corretamente as embalagens e restos de produtos.